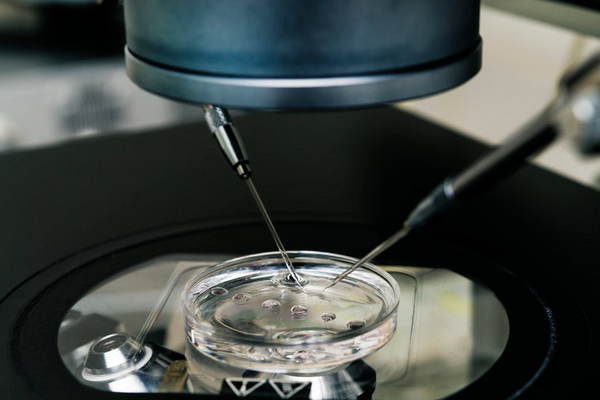
58b01e706654c1e4bfa08b08e21c31a7.png 上海试管婴儿有什么优势

现在生活压力越来越大,生活工作负担越来越重,很多年轻人都有生育问题,自然目光就会放在试管婴儿技术上。那么,上海哪个医院试管成功率最高呢?上海医院做试管婴儿有什么优势呢?
上海哪个医院试管婴儿成功率最高
1、上海市第一妇婴保健院
上海市第一妇婴保健院辅助生殖医学科在2006年通过审批,是上海较早开展辅助生殖技术的医疗机构之一。临床试管成功率约为40%-65%。医院拥有庞大的医生团队和丰富的临床经验。

2、上海交通大学医学院附属仁济医院
上海仁济医院生殖医学中心在2001年。该院实施个性化、针对性的治疗方案,使得该院试管婴儿成功率稳步提升,临床试管婴儿成功率在40%左右。
3、中国福利会国际和平妇幼保健院
中国福利会国际和平妇幼保健院生殖医学科成立于2000年,2001年获准开展体外受精、胚胎移植、卵胞浆内单精子显微注射技术。临床试管婴儿成功率大概在40%-65%,这家医院的科室极其全面。
在上海医院做试管婴儿有什么优势
1、上海医院医疗水平高,医疗用品有保障。
2、上海的试管婴儿医院成功率高。上海聚集了大量的医学专家和人才。看病的人多了,医生经验就多了,试管婴儿的成功率自然就高了。
3、上海的公共服务比较完善,基础设施很好,交通很发达。无论去哪里,都有公交或地铁覆盖,就医也有很多替代路线。
4、上海试管在中国起步早,发展时间长,案例多,技术成熟,经验丰富。
总的来说,上海做试管婴儿的各家医院试管成功率差别不是很多,且每家医院都有自身的优势,想要做试管婴儿的患者可以依据自身患有的疾病及需求到对应的医院进行咨询,以便能够选择最合适的医院做试管婴儿,促使试管婴儿的成功率得到提升和保障。
